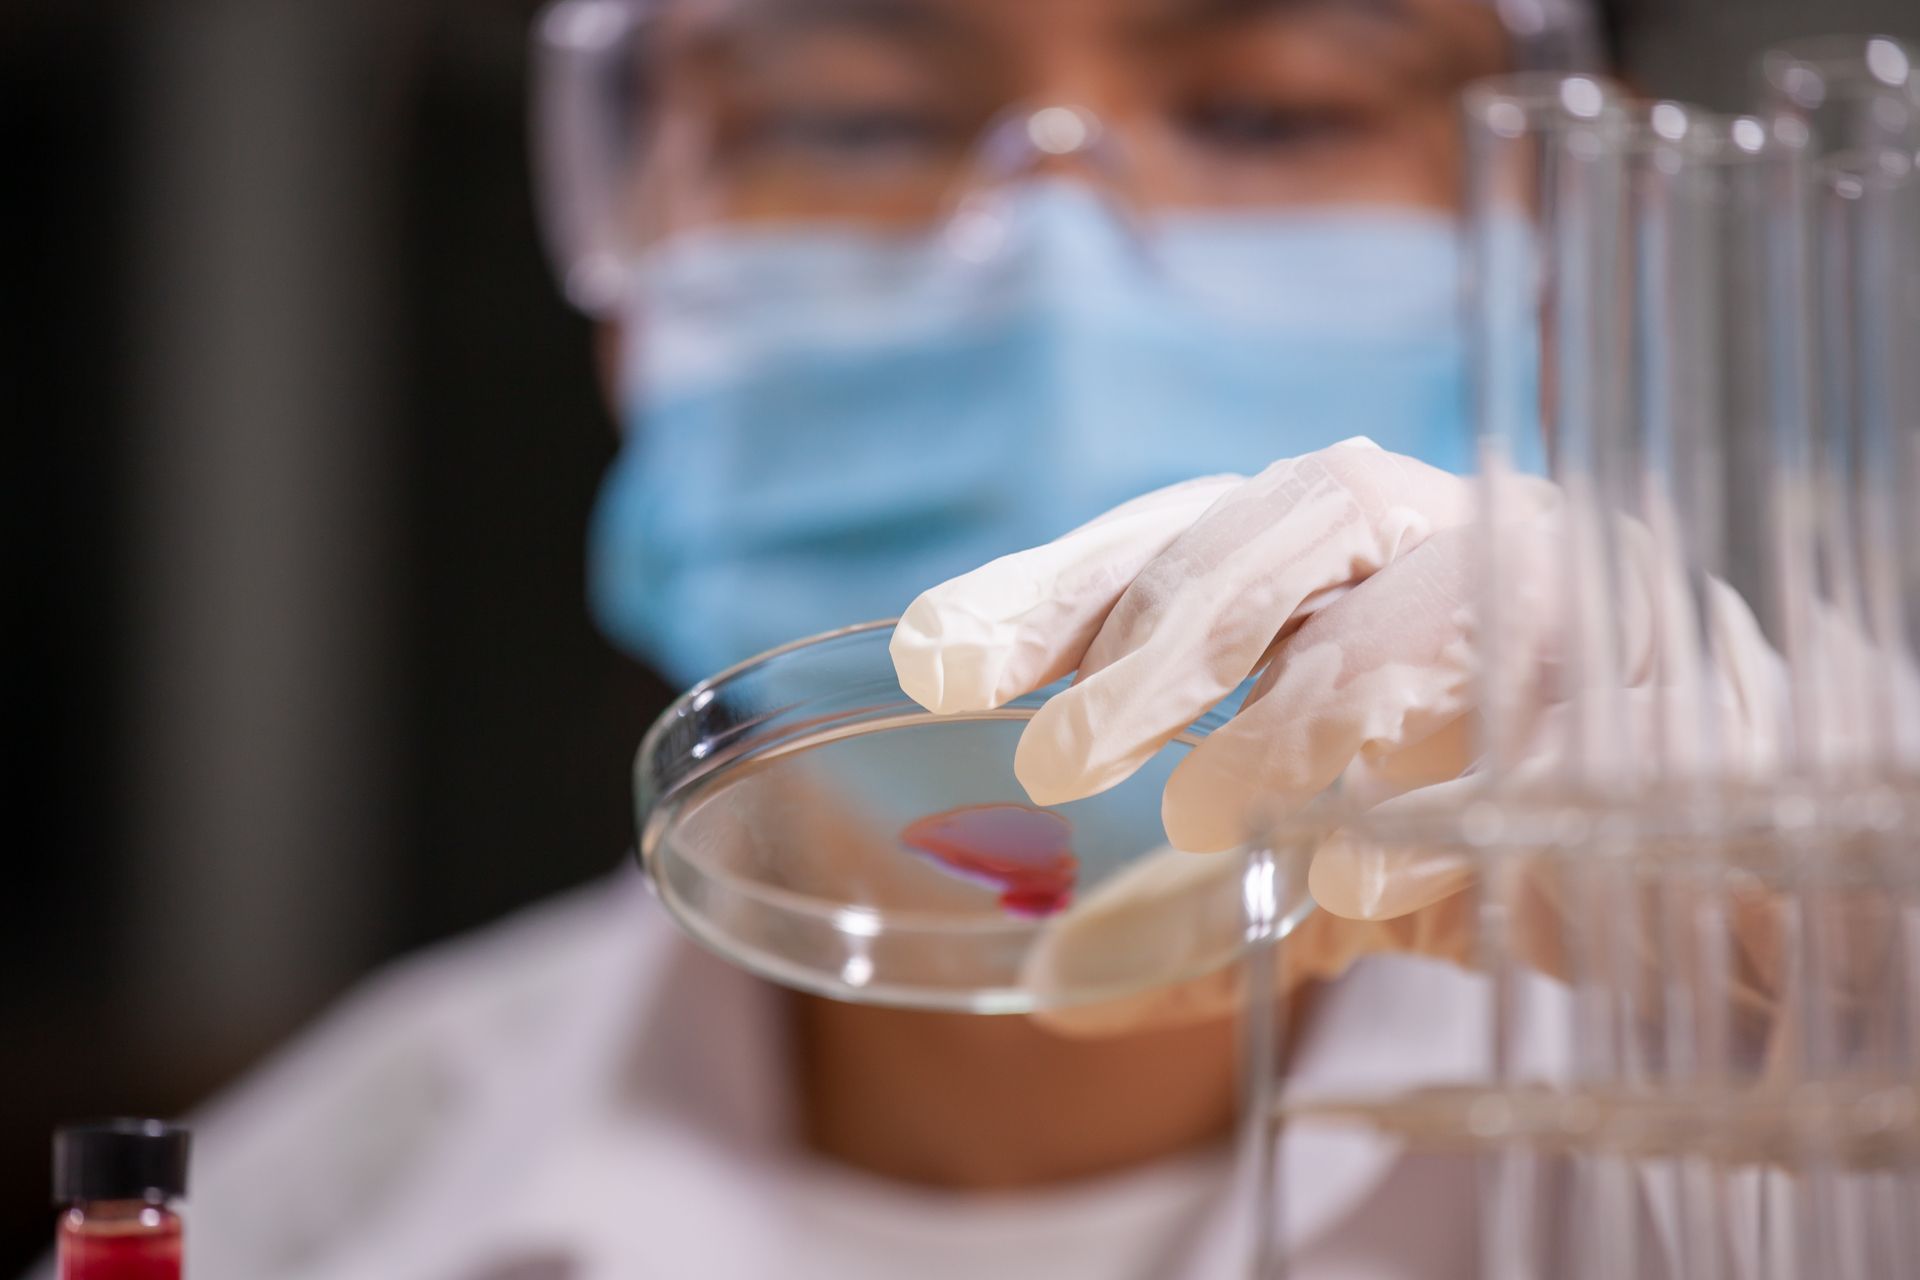

Bioscience Research Laboratories
BSL serves as the central hub for bioscience research, including microbiological testing, food and water analysis, phytochemical extraction, and animal bioassays. It houses specialized laboratories such as the animal facility, microbiology, and chemical analysis labs. BSL also provides services to academic and hospital units, including culture media preparation and cryopreservation of biological specimens.
SERVICES OFFERED

Animal Bioassays
Tests that involve living organisms in assessing the effects of substances, such as drugs, chemicals, or toxins, typically conducted to determine their safety
or toxicity.

Use of Laboratory
Animal Facility
Providing access to controlled environments housing laboratory animals for experimentation, ensuring optimal conditions for research involving
live specimens.
Cell and Tissue Studies
For examining cellular and tissue-level responses to various stimuli, aiding in understanding biological processes, disease mechanisms, and potential therapeutic interventions.


Microbiological Tests
Tests that involve the analysis of microorganisms such as bacteria,
and fungi, often conducted to identify pathogens and assess
antimicrobial susceptibility.

Bacterial Culture
Maintaining a collection of bacterial specimens cultured from various sources, serving as a resource for research, diagnostic, and educational purposes.

Food and Water Analysis
Testing food and water samples for contaminants, pathogens, nutritional content, and other quality parameters, ensuring safety and compliance with regulatory standards.

Phytochemical Extraction and Analysis
For the isolation and analysis of bioactive compounds from plant materials, exploring their potential applications in medicine, nutrition, agriculture, and
other fields.
Microbiological Culture Media Preparation
Preparing specialized growth media tailored to support the cultivation and isolation of specific microorganisms, facilitating microbiological research
and diagnostics.
Cryopreservation of Microbiological and Biological Specimens
Maintaining microbial cultures, cell lines, tissues, and other biological materials at ultra-low temperatures, enabling long-term storage and conservation of valuable research resources.

Contact Us
Bioscience Research Laboratories
Rm. 5100, Ground Floor, Lourdes E. Campos, MD Building
De La Salle Medical and Health Sciences Institute
Governor D. Mangubat Avenue, Zone IV, City of Dasmariñas, Cavite, Philippines
+63 (2) 8988-3100 (Manila)
+63 (46) 481-8000 (Cavite)
Local no.: 1376 / 1383
PHONE
Monday to Friday
8:00 AM - 5:00 PM


